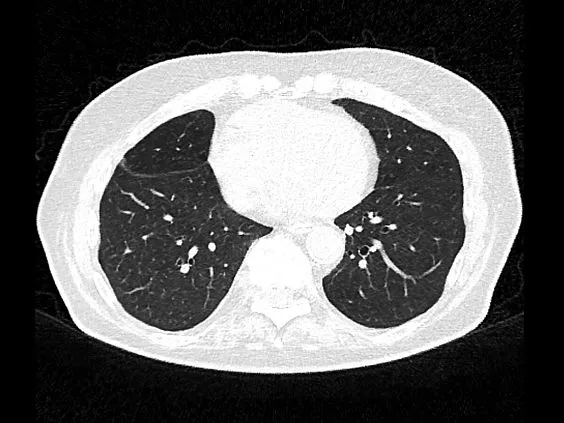

Siemens SOMATOM go.Now компьютерный томограф
Клинические изображения
Характеристики
- Количество физических срезов: 16
- Всего срезов (max количество): 32
- Время оборота - 1,5; 1,0 c (опция 0,8 с)
- Макс. теплоемкость анода - 3,5 млн ТЕ (8,75 млн ТЕ)1
- Номинальная выходная мощность анода - до 34 кВт (80 кВт)
- Напряжение трубки - 80; 110; 130 кВ
- Максимальный ток - 240 мА (опция 400 мА), 600 мА (опция 1000 мА)
- Ширина детектора - 1,1 см (16 x 0,7 мм)
- Макс. нагрузка на стол - 160 (опция 227 кг)
- Алгоритм итеративной реконструкции - SAFIRE
- Опциональные возможности — ангиография, виртуальная колоноскопия, технология скопии
Описание
Компьютерный томограф SOMATOM go.Now основан на новом мобильном рабочем процессе. В нем реализован ряд инновационных решений, которые обеспечивают высокий уровень гибкости и мобильности в повседневных КТ-исследованиях. Эти решения также помогают повысить уровень комфорта для пациента и в перспективе обеспечат высокий уровень их удовлетворенности. Вы можете заказать или купить со склада в наличии Siemens SOMATOM go.Now компьютерный томограф по выгодной цене, от надежного официального дистрибьютора «МСТ», с бесплатной доставкой в любой город по всей России.
Технические характеристики
- Количество физических срезов: 16
- Всего срезов (max количество): 32
- Время оборота - 1,5; 1,0 c (опция 0,8 с)
- Макс. теплоемкость анода - 3,5 млн ТЕ (8,75 млн ТЕ)1
- Номинальная выходная мощность анода - до 34 кВт (80 кВт)
- Напряжение трубки - 80; 110; 130 кВ
- Максимальный ток - 240 мА (опция 400 мА), 600 мА (опция 1000 мА)
- Ширина детектора - 1,1 см (16 x 0,7 мм)
- Макс. нагрузка на стол - 160 (опция 227 кг)
- Алгоритм итеративной реконструкции - SAFIRE
- Опциональные возможности — ангиография, виртуальная колоноскопия, технология скопии
Особенности и преимущества системы
Главной особенностью новинки стало управление при помощи планшетного компьютера, который заменяет пульт оператора и обеспечивает аппаратам большую мобильность.
- Больше времени проводится с пациентом, а не с компьютером;
- Простой интерфейс;
- Снижено время подготовки к исследованию;
- Автоматическая постобработка исследования;
- Увеличено поле обзора.
В комплектацию этого аппарата входят инновационные разработки и технологии по оптимизации рабочих процессов и удобства пользования, которые повышают эффективность работы с компьютерным томографом, независимо от опыта каждого отдельного оператора. Они обеспечивают отличные результаты во время рутинных исследований. А полностью модернизированная модель обслуживания в сочетании с усовершенствованным рабочим местом позволяют сократить расходы.
Проведение скрининга заболеваний легких (доза на уровне обычной рентгенографии) и ангиография c меньшим объемом контрастного вещества.
- Еще большое снижение шума, апертура 70 см;
- Крепление инжектора на гентри, позволяя быстро привести его в нужное положение;
- Встроенная в гентри камера позволяет повысить качество исследования;
- Рабочая станция лаборанта на планшете высокого разрешения, позволит уделить больше внимания пациенту в процедурной.